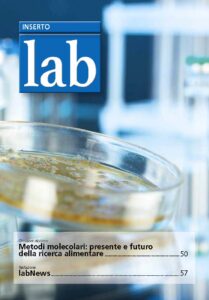

Proteggere la salute delle persone, degli animali e delle piante in ogni singola fase del processo di produzione alimentare è una delle principali priorità per la “public health” e l’economia. Per capire perché in questo contesto è fondamentale determinare i contaminanti biologici e individuare le corrette metodiche per rilevarli, il portale Alimenti&Bevande nel suo inserto “LAB” ha intervistato Vincenzina Fusco, primo ricercatore presso l’Istituto di Scienze delle Produzioni Alimentari.

Comments
Comments are closed.